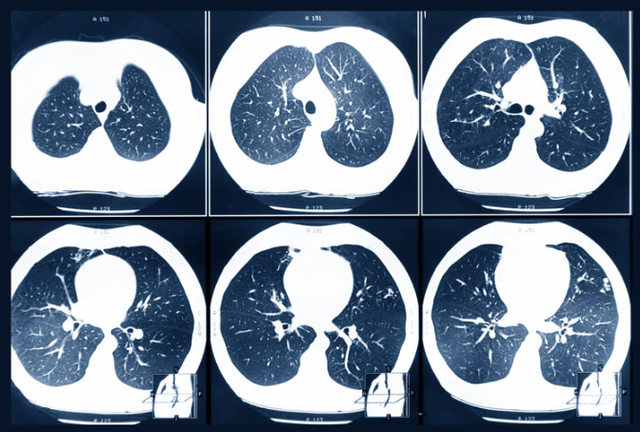

李阿姨今年58岁,退休在家,平时身体还算硬朗。她一直觉得自己没啥毛病,每年单位安排体检,也只是做个血常规、量个血压就完事儿,图个安心。
可去年底,她突然感觉肚子隐隐作痛,原以为是胃不舒服,拖了两个月才去医院。结果一查,是肠癌晚期。
“我明明每年都体检,怎么还会得癌?”她难以接受这个结果。
医生摇头叹气:“有些关键项目,您年年都没做,病灶早就藏在里面了。”
听完医生的话,李阿姨才知道,体检并不是走个过场,特别是上了年纪的人,一些深层次的检查更不能忽视。
 年年体检,为何突然确诊癌症?
年年体检,为何突然确诊癌症?体检的核心目的是通过一系列检查项目,评估身体的基本健康状况。常见的体检项目包括血常规、尿常规、肝功能、肾功能、心电图等。这些检查能够发现一些常见的健康问题,比如高血压、高血糖或肝脏异常,部分癌症也能在体检中及时被发现。
美国国家癌症研究所(National Cancer Institute)在2019年发布的研究显示,定期乳腺癌筛查可以将死亡率降低20%至40%。这项研究基于多年的数据分析,证明了针对性检查能够帮助女性在癌症早期被发现,从而提高治愈的机会。

世界卫生组织(World Health Organization)在2018年的报告指出,定期的宫颈癌筛查可以将发病率和死亡率降低80%以上。这项数据是通过全球范围内的筛查项目统计得出的,显示出专业筛查在预防宫颈癌方面的巨大作用。
但癌症的发生和发展是一个渐进的过程,不同类型的癌症进展速度差异很大。有些癌症在早期阶段非常隐秘,几乎没有任何症状,直到发展到中晚期才会表现出明显的异常。
比如,胰腺癌的早期可能只有轻微的腹痛,而肺癌早期可能只有偶尔咳嗽,这些症状在体检中很难被识别出来。更重要的是,有些癌症可以在两次体检之间的时间里快速恶化。

常规体检套餐通常只包含基础检查,而癌症的早期筛查需要更专业、更针对性的项目。比如,要发现早期肺癌,可能需要低剂量CT扫描;要筛查结直肠癌,可能需要结肠镜检查。
这些检查项目通常不在常规体检范围内,尤其是对于没有明显症状的普通人群来说,医生也不会轻易建议做这些检查。这就导致一些隐匿性强的癌症,比如胰腺癌、卵巢癌,在常规体检中很难被发现。
 这5项检查,不能漏!
这5项检查,不能漏!体检不光要定期做,还要做得全面,早期发现问题,才能早做打算,有效预防或者治疗。有几项检查作用远比你想象的大,千万不要为了图省事就漏了它们。
1.肿瘤标志物检查。
肿瘤标志物,简单来说,就是一些可以反映癌症早期变化的物质。虽然不能单靠它来确诊癌症,但做这个检查能帮你看看是不是有潜在的癌症风险。
比如,肝癌、肺癌、胃癌等,它们在早期往往没有明显的症状,肿瘤标志物检查可以作为早期筛查的一个重要参考。这个检查特别适合中老年人,身体各项机能逐渐下降,癌症的风险也会相应增高。

2.结肠镜检查
结肠镜检查是发现肠道疾病的一项非常有效的方法。很多人到了一定年纪后,会出现肠胃不舒服的情况,可能是由于饮食不规律、便秘等因素引起的,可是这些症状有时并不能反映出肠道是否有重大问题。
通过结肠镜检查,医生能够直视肠道内部,查出息肉、溃疡甚至早期癌变。年龄超过50岁的人,尤其有家族癌症史的,最好每5年做一次。

3.乳腺X线检查(乳腺钼靶)
乳腺癌是女性常见的癌症之一,早期常常没有症状,所以定期做乳腺X线检查非常重要。
通过这个检查,能够早期发现乳腺内的小肿块,哪怕是只有几毫米大的肿块也能被发现,及时处理,能有效提高治愈率。
特别是40岁以上的女性,如果家里有乳腺癌的病史,更应该关注这个检查,最好每年做一次。

4.骨密度检测。
随着年龄的增长,人体的骨密度会逐渐降低,骨质疏松的风险增加。这个时候,做一次骨密度检测,可以帮助你了解自己骨头的健康状况,特别是对于女性来说,骨密度下降的速度比男性快,特别是在绝经后。

5.糖尿病筛查
糖尿病是目前全球范围内越来越常见的慢性病,特别是随着人们生活方式的改变,肥胖、缺乏运动等因素增加了患糖尿病的风险。
糖尿病往往没有明显症状,尤其是早期,很多人都没感觉到自己已经患病。但血糖水平一旦升高,就会对身体各个器官造成损害,严重时会影响心脏、肾脏、眼睛等。
定期做血糖检查,能够帮助你早期发现糖尿病的征兆,及时调整饮食和生活习惯,避免发展成严重的并发症。
 这3个指标记得留心
这3个指标记得留心每年去做体检,大家可能都关注常规的那些项目,比如血压、血糖、肝功能等。可有些指标其实也很重要,它们能帮我们提前发现一些不容易察觉的健康问题,尤其是一些潜在的疾病。
1.肝功能检查
肝功能检查主要是检测肝脏是否受损,常见的检查项目包括ALT、AST、总胆红素等。
如果这些指标异常,可能说明肝脏出现了问题,比如肝炎、脂肪肝,或者更严重的肝硬化等。肝脏不健康,身体就会受影响,免疫力下降,甚至引发其他器官的疾病。
别觉得肝功能检查很常见,就忽视它。通过这个检查,能及早发现问题,及时采取措施,防止病情发展。
2.血脂水平
很多人对血脂检查的重视程度不够,觉得只要不吃油腻食物就没事了。其实,血脂异常是心血管疾病的一个重要危险因素。
特别是“坏”胆固醇(低密度脂蛋白,LDL)过高,容易在血管壁上堆积,形成动脉粥样硬化,最终可能导致心脏病或中风。而“好”胆固醇(高密度脂蛋白,HDL)不足,则无法有效清除血管中的多余脂肪,增加了患病的风险。
如果发现自己的血脂偏高,就要开始调整饮食和生活方式,控制油脂摄入,增加运动量,甚至必要时使用药物治疗,降低心脑血管疾病的风险。

3.血糖水平
血糖升高是糖尿病的直接表现,但它的“隐匿性”也很强。很多人血糖偏高时并没有明显症状,可能就是容易疲倦、偶尔口渴或多尿,这些症状很容易忽略。
而一旦血糖长期过高,就会对身体的各个器官造成损害,尤其是心脏、肾脏、眼睛和神经系统。
因此,定期监测血糖非常重要。特别是40岁以上的人,血糖检查应该成为常规体检的一部分。通过早期发现和干预,能够有效预防糖尿病并发症,保持身体各项功能的正常运作。

体检的意义在于“防患于未然”,而不是“查出问题才后悔”。多花一点时间做全面检查,可能就多赢得几十年的安心人生。
参考资料:
[1] 《身体一直很正常,为什么会突然查出癌?》.健康时报.2024-07-15
[2] 《体检不做5个检查,得了癌症都不知道,这些部位最好定期体检一下》.DrX说.2025-02-24
[3] 《忽视了4个字,他错失肺癌根治机会!体检报告出现这些“字眼”要当心》.健康时报.2024-06-12